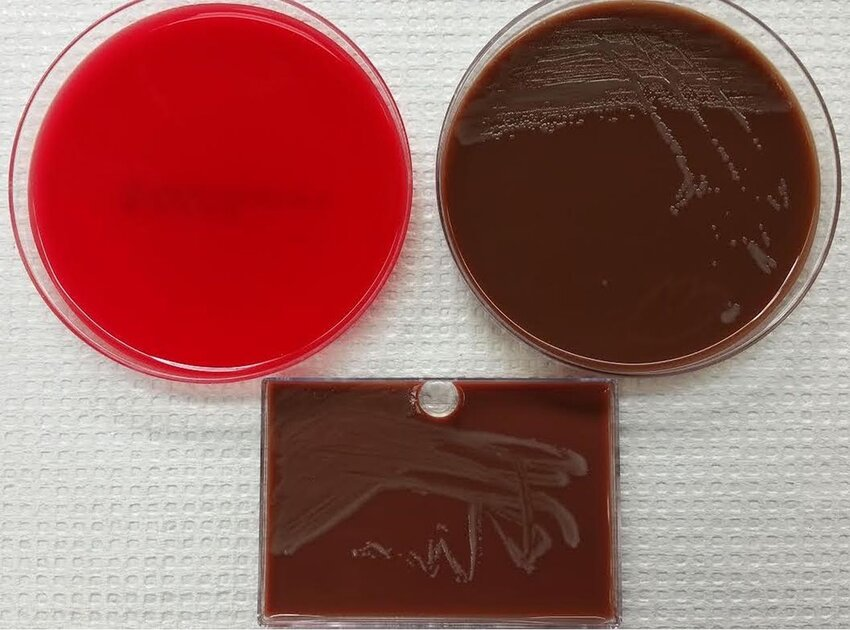

Κορίτσι 16 ετών προσέρχεται στα επείγοντα με οξύ κοιλιακό άλγος. Έχει θερμοκρασία 38.5°C και εργαστηριακά διαπιστώνεται λευκοκυττάρωση και αυξημένη ΤΚΕ. Στη φυσική εξέταση διαπιστώνεται ευαισθησία στην ψηλάφηση της κοιλίας. Η γυναικολογική εξέταση αποκαλύπτει πυώδες έκκριμα από τον τράχηλο της μήτρας και άλγος στην αμφίχειρη εξέταση. Αποστέλλεται γενική εξέταση ούρων, τέστ κυήσεως και καλλιέργεια τραχηλικού υγρού. Η Gram χρώση του τραχηλικού υγρού φαίνεται στην εικόνα. Από το ιστορικό αναφέρει ότι είχε περίοδο πριν 4 ημέρες και ότι είχε για πρώτη φορά σεξουαλική επαφή πριν ένα χρόνο, ενώ πρόσφατα απέκτησε νέο σεξουαλικό σύντροφο. Δεν έχει χρησιμοποιήσει ποτέ προφυλακτικό ή οποιοδήποτε μέτρο αντισύλληψης.

Ερωτήματα
- Τι εξετάσεις πρέπει να ζητηθούν για το τραχηλικό υγρό; Τι είναι το πιθανότερο να αποκαλύψει η χρώση;
- Αν όντως το κορίτσι έχει φλεγμονώδη νόσο της πυέλου (ΦΝΠ) πώς την απέκτησε;
- Έχει σημασία η φάση του κύκλου στην οποία βρίσκεται;
- Ποιά αίτια ΦΝΠ πρέπει να σκεφθούμε;
- Η χρήση προφυλακτικού θα είχε αποτρέψει τη ΦΝΠ σε αυτή την περίπτωση; Η εφαρμογή άλλων μέτρων αντισύλληψης / προστασίας θα είχε αποτρέψει τη λοίμωξη;
- Ποιά άλλα οφέλη θα είχε το κορίτσι αν ο σύντροφός της και αυτή χρησιμοποιούσαν συστηματικά και σωστά τα προφυλακτικά;
Απαντήσεις πιο κάτω …

Η Neisseria gonorrhoeae είναι Gram-αρνητικός καφεοειδής διπλόκοκκος αυξημένων διατροφικών απαιτήσεων. Συνήθως δεν αναπτύσσεται ούτε στο θρεπτικό (nutrient) ούτε στο αιματούχο άγαρ. Αναπτύσσεται σε εμπλουτισμένο σοκολατόχρωμο άγαρ και άλλα εμπλουτισμένα θρεπτικά υλικά σε θερμοκρασία 35-37°C (πεθαίνει εύκολα σε χαμηλότερες θερμοκρασίες) και ατμόσφαιρα με υγρασία και 5% CO2. Αν δεν πληρούνται αυτές οι προϋποθέσεις δεν μπορεί να απομονωθεί σε καλλιέργεια.
Η δομή της είναι η τυπική ενός gram-αρνητικού βακτηρίου με λεπτό στρώμα πεπριδογλυκάνης και εξωτερική μεμβράνη, ενώ ΔΕΝ έχει, (όπως η N.meningitidis) πολυσακχαριδικό έλυτρο. Διαθέτει επίσης:

- ινίδια (πρωτεΐνη πιλίνη) που βοηθούν στην προσκόλληση στα επιθήλια
- πρωτεΐνες Por στην εξωτερική μεμβράνη που λειτουργούν ως κανάλια για θρεπτικά συστατικά, εμποδίζουν την αποκοκκίωση των πολυμορφοπυρήνων και διευκολύνουν τη διείσδυση σε επιθηλιακά κύτταρα
- πρωτεΐνες Opa για προσκόλληση και διείσδυση σε κύτταρα
- λιποολιγοσακχαρίτη (LOS) αποτελούμενο από λιπίδιο Α και κεντρικό πολυσακχαρίτη (όχι Ο αντιγόνο) με δράση ενδοτοξίνης
- επιφανειακούς υποδοχείς για την τρανσφερρίνη (για προσπορισμό σιδήρου από τον ξενιστή)
- IgA1 πρωτεάση για διάσπαση της IgA των βλεννογόνων
- β-λακταμάση που διασπά την πενικιλλίνη
Η γονόρροια είναι νόσος μόνο του ανθρώπου. Προσβάλλονται εξίσου άνδρες και γυναίκες. Μέγιστο επίπτωσης σε ηλικίες 15-24 ετών. Δεξαμενή : μόνον ο άνθρωπος, οι ασυμπτωματικοί φορείς (συχνότερα γυναίκες). Μεταδίδεται :
- με σεξουαλική επαφή (κίνδυνος 50% για τη γυναίκα, 20% για τον άνδρα / επαφή με μολυσμένο σύντροφο). Παράγοντας κινδύνου οι πολλαπλοί σεξουαλικοί σύντροφοι.
- περιγεννητικά (= κατά τον φυσιολογικό τοκετό) από μολυμένη μητέρα στο νεογνό
Προσβάλλονται το επιθήλιο της ουρήθρας στον άνδρα, το επιθήλιο του ενδοτραχήλου και της ουρήθρας στη γυναίκα, ο επιπεφυκώς κυρίως στα νεογνά, το επιθήλιο του φάρυγγα και το επιθήλιο του ορθού και στα δύο φύλα. H N. gonorrhoeae προσβάλλει κυλινδρικό ή μεταβατικό αλλά όχι πλακώδες επιθήλιο. Συνεπώς, προκαλεί τραχηλίτιδα ΑΛΛΑ ΟΧΙ κολπίτιδα στις γυναίκες μετά την εφηβεία. Μετά από 2-5 ημ επώαση…
Κλινικά η λοίμωξη εκδηλώνεται ως
- ουρηθρίτιδα στον άνδρα (δυσουρία, καύσος, πυώδες έκκριμα). Η λοίμωξη στον άνδρα σχεδόν πάντα συμπτωματική. Πιθανές (σπάνιες) επιπλοκές : επιδιδυμίτιδα, προστατίτιδα, περιουρηθρικά αποστήματα.
- τραχηλίτιδα στη γυναίκα (έκκριμα δυσουρία, κοιλιακό άλγος). Σε 10-20% ανιούσα λοίμωξη (σαλπιγγίτιδα, σαλπιγγοωοθηκικά αποστήματα, ΦΝΠ). Η λοίμωξη στη γυναίκα συχνά ασυμπτωματική, κίνδυνος ΦΝΠ, έκτοης κύησης, στειρότητας, διάχυτης λοίμωξης.
- γονοκοκκαιμία. Διασπορά του μικροβίου στο αίμα (1-3% στις γυναίκες, λιγότερο στους άνδρες) με αποτέλεσμα σηψαιμία, αρθρίτιδα, φλυκταινώδεις δερματικές βλάβες.
- Περιηπατίτιδα (σύνδρομο Fitz-Hugh–Curtis)
- πυώδης επιπεφυκίτιδα (νεογνική οφθαλμία, ophthalmia neonatorum) σε νεογνά που γεννήθηκαν με φυσιολογικό τοκετό από μολυσμένες μητέρες
- ορθοπρωκτίτιδα (συχνότερα σε ομοφυλόφιλους άνδρες)
- φαρυγγίτιδα
Εργαστηριακά η διάγνωση περιλαμβάνει:

- Μικροσκόπηση εκκρίμματος μετά χρώση Gram : >90% ευαισθησία 98% ειδικότητα ΣΤΟΥΣ συμπτωματικούς ΑΝΔΡΕΣ. Στις γυναίκες δεν είναι αξιόπιστο το αρνητικό αποτέλεσμα. Στις άλλες λοιμώξεις (εκτός της αρθρίτιδας) δεν είναι βοηθητική.
- Μοριακές μέθοδοι (ΝΑΑΤs) : μέθοδος αναφοράς (ελέγχουν ταυτόχρονα και για άλλα ΣΜΝ)
- Καλλιέργεια σε σοκολατόχρωμο (ή Thayer – Martin άγαρ για δείγματα από περιοχές με χλωρίδα). Απαιτείται ταχύτατος ενοφθαλμισμός (δίπλα στον ασθενή) γιατί είναι εξαιρετικά ευαίσθητες στην αποξήρανση και τις χαμηλές θερμοκρασίες.
- Ταυτοποίηση : προκαταρκτική : gram-αρνητικός διπλόκοκκος, οξειδάση θετικός, ανάπτυξη στο σοκολατόχρωμο άγαρ. Τελική ταυτοποίηση : δοκιμασία οξείδωσης υδατανθράκων (N.gonorrhoeae μόνο τη γλυκόζη) ή MALDITOFF (φασματομετρία μάζας).
Θεραπεία : συνδυασμός κεφτριαξόνη και αζιθρομυκίνης
Πρόληψη: Δεν υπάρχει εμβόλιο (αντιγονική μεταβολή σημαντικότερων αντιγόνων). Χημειοπροφύλαξη νεογνών με κολλύριο νιτρικού αργύρου, 1%, τετρακυκλίνης 1% ή οφθαλμική αλοιφή ερυθρομυκίνης 0.5%. Επιμόρφωση για ασφαλείς σεξουαλικές πρακτικές και χρήση προφυλακτικών.
Απαντήσεις
1.Τι εξετάσεις πρέπει να ζητηθούν για το τραχηλικό υγρό; Τι είναι το πιθανότερο να αποκαλύψει η χρώση;
Η κλινική εικόνα της κοπέλας είναι συμβατή με λοίμωξη από γονόκοκκο (Neisseria gonorrhoeae) ή από χλαμύδια (Chlamydia trachomatis ορότυποι D-K).
Εργαστηριακά μπορεί : α. να παραγγελθεί έλεγχος με μοριακές μεθόδους και για τα δύο παθογόνα από το ίδιο δείγμα. β. Να ενοφθαλμισθεί επί τόπου καλλιέργεια για Neisseria gonorrhoeae. Η ταχύτερη διαγνωστική μέθοδος είναι η Gram-χρώση τραχηλικού υγρού στην οποία φαίνονται Gram-αρνητικοί διπλόκοκκοι φαγοκυτταρωμένοι από πολυμορφοπύρηνα ουδετερόφιλα (πυοσφαίρια). Η εικόνα αυτή είναι έντονα ενδεικτική γονοκοκκικής λοίμωξης. Ωστόσο η χρώση Gram έχει μεγαλύτερη διαγνωστική αξία σε συμπτωματικούς άνδρες.
2. Αν όντως το κορίτσι έχει φλεγμονώδη νόσο της πυέλου (ΦΝΠ) πώς την απέκτησε;
Πιθανότατα από σεξουαλικό σύντροφο που ενδεχομένως είχε ασυμπτωματική λοίμωξη από N. gonorrhoeae.
3. Έχει σημασία η φάση του κύκλου στην οποία βρίσκεται;
Ναι. Η διασπορά από τον τράχηλο και μέσα από τη μήτρα στις σάλπιγγες είναι πιθανότερο να συμβεί σε αυτή τη φάση του κύκλου λόγω της μικρότερης προστασίας που προσφέρει η τραχηλική βλέννη.
4. Ποιά αίτια ΦΝΠ πρέπει να σκεφθούμε;
Εκτός από το γονόκοκκο συχνό αίτιο ΦΝΠ είναι και τα Chlamydia trachomatis. Μετά από πολλαπλές προσβολές, στην λοίμωξη μπορούν να εμπλακούν δευτεροπαθώς εντεροβακτηριακά και αναερόβια μικρόβια.
5. Η χρήση προφυλακτικού θα είχε αποτρέψει τη ΦΝΠ σε αυτή την περίπτωση; Η εφαρμογή άλλων μέτρων αντισύλληψης / προστασίας θα είχε αποτρέψει τη λοίμωξη;
Ναι, η χρήση προφυλακτικού θα είχε αποτρέψει τη μετάδοση του μικροβίου. Το καλύτερο μέτρο πρόληψης είναι τα προφυλακτικά. Τα σπερματοκτόνα τζελ έχουν κάποια βακτηριοκτόνο επίδραση, αλλά δεν έχουν αποδειχθεί αποτελεσματικά για τη ΦΝΠ, ενώ η παρατεταμένη χρήση μπορεί να ευοδώσει τη μετάδοση HIV. Τα αντισυλληπτικά χάπια δεν παρέχουν καμμία προστασία από τη μετάδοση ΣΜΝ.
6.Ποιά άλλα οφέλη θα είχε το κορίτσι αν ο σύντροφός της και αυτή χρησιμοποιούσαν συστηματικά και σωστά τα προφυλακτικά;
Θα μείωνε τον κίνδυνο ανεπιθύμητης εγκυμοσύνης, και θα απέφευγε τις επιπλοκές της ΦΝΠ, όπως έκτοπη κύηση, χρόνιο πυελικό άλγος, υποτροπιάζουσα ΦΝΠ και τελικά στειρότητα.
Πηγές : Murray K et al – Medical Microbiology (2020), Schaechter’s Mechanisms of Microbial disease (2012)
Εικόνες
https://ar.inspiredpencil.com/pictures-2023/neisseria-gonorrhoeae-gram-stain
